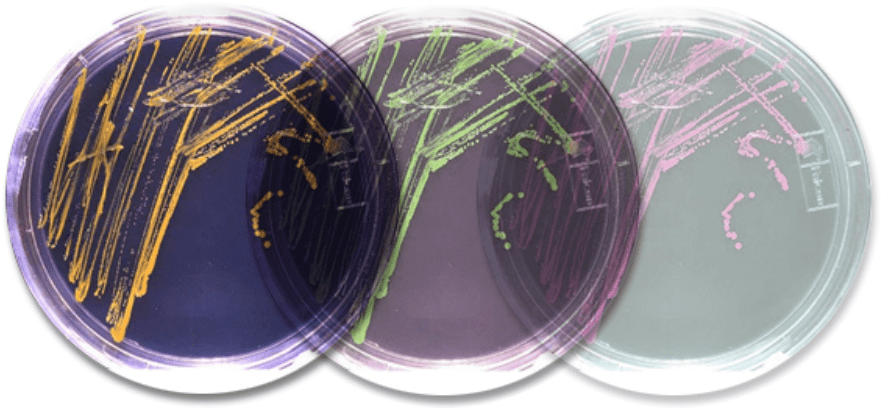

Biodiversidad del Suelo y Biotecnología
Los altos niveles de Biodiversidad que se encuentran en el sistema del suelo incluyen organismos que realizan una amplia gama de funciones ecológicamente importantes. Los organismos que habitan en el suelo, al igual que los organismos de la superficie, deben competir por los recursos y tratar de evitar ser presas hasta que logren reproducirse.
Las consecuencias de esto es que se están produciendo muchas “carreras armamentistas” evolutivas dentro del sistema del suelo. Esto, combinado con los altos niveles de diversidad, significa que hay una serie de funciones y compuestos dentro del sistema del suelo que pueden utilizarse para aplicaciones biotecnológicas, y potencialmente hay muchas más funciones y compuestos que podrían ser útiles y que aún no se han descubierto. Por este motivo, un área activa de la investigación biológica del suelo es la de la Biotecnología.
Las áreas de investigación biotecnológica generalmente se incluyen en una o más de los siguientes ámbitos:
Biorremediación
La biota del suelo alberga muchos descomponedores diferentes. Estos son organismos heterótrofos que descomponen sustancias orgánicas para ganar energía y, al hacerlo, reciclan Carbono y Nitrógeno de vuelta al medio ambiente.
Este proceso también se puede utilizar como una forma de biotecnología conocida como biorremediación, que es el proceso de utilizar organismos (“bio”) para devolver un área contaminada a su estado natural (“remediación”).
A pesar de esta amplia definición, la mayor parte de la biorremediación en realidad se lleva a cabo mediante el uso de microorganismos debido a su capacidad para utilizar una gran gama de fuentes de Carbono como sustrato.
Diferentes descomponedores del suelo son capaces de degradar diferentes tipos de sustancias orgánicas. Algunos compuestos no son recalcitrantes y, por lo tanto, son susceptibles a la descomposición por parte de una variedad de organismos. Otros compuestos, como la lignina y la celulosa, son muy recalcitrantes y sólo susceptibles de descomponerse por unos pocos organismos selectos; por ejemplo, los hongos causantes de la pudrición parda en el caso de la lignina. Esto significa que algunos contaminantes no recalcitrantes pueden durar sólo un período corto en el medio ambiente y ser descompuestos sin la intervención humana. Sin embargo, muchos contaminantes orgánicos están compuestos de largas cadenas de Carbono e Hidrógeno y pueden ser estructuralmente similares a compuestos orgánicos complejos como la lignina. Estos compuestos generalmente duran mucho más tiempo en el medio ambiente, pero las similitudes en la estructura significan que los hongos frecuentemente pueden usarse para la biorremediación de muchos tipos de compuestos, siendo la clave la determinación de la cantidad correcta de especies de hongos para lograr una biorremediación eficaz de un compuesto determinado.
La increíble diversidad de bacterias significa que generalmente también existen tipos de bacterias capaces de degradar contaminantes. Nuevamente, es necesario determinar el tipo correcto de bacteria para un contaminante determinado a fin de lograr la máxima eficacia de la biorremediación.
La biorremediación ocurre o se lleva a cabo de tres formas diferentes:
Biorremediación intrínseca: Este proceso ocurre naturalmente en suelos o aguas contaminadas y es llevado a cabo por microorganismos que viven en el lugar de la contaminación. No se requieren organismos ni nutrientes adicionales.
Bioestimulación: En este proceso, se agregan nutrientes y/u oxígeno al suelo contaminado (o agua contaminada) para estimular el crecimiento y la actividad de los microorganismos que viven en el sitio de la contaminación.
Bioaumentación: Es el proceso de introducir organismos, generalmente microorganismos al suelo (o agua), para ayudar a la biorremediación intrínseca; o introducir organismos capaces de degradar un contaminante que la población intrínseca no puede degradar.
La biorremediación puede ser muy eficaz para eliminar contaminantes de los sitios afectados. En un caso por ejemplo, un volumen de suelo de 38 000 m3 en Canadá fue contaminado por una planta de gasificación con un subproducto de alquitrán de petróleo que contiene hidrocarburos aromáticos policíclicos, cianuro, xileno, tolueno y metales pesados. Después de la aplicación de una bacteria y una mezcla de nutrientes nitrogenados (una combinación de técnicas de bioestimulación y bioaumentación), los diversos contaminantes constituyentes del alquitrán de petróleo se redujeron entre un 40 y un 90 por ciento en sólo 70 a 90 días (Warith et al. 1992)
Referencia:
Gardi Ciro and Jeffery Simon. Soil Biodiversity. Joint Research Centre, Scientific and Technical Reports Institute for Environment and Sustainability. Land Management & Natural Hazards Unit.